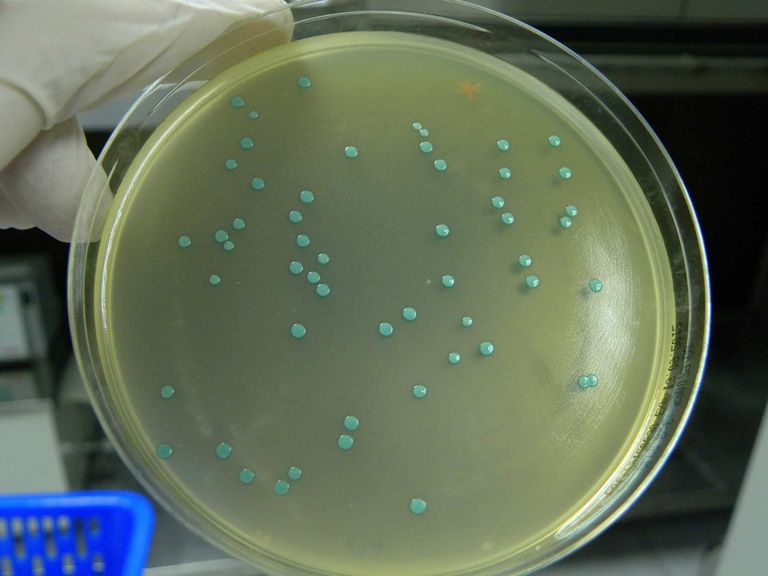

أترغب في تفعيل الإشعارات؟
حتى لا تفوتك آخر الأحداث والأخبار العاجلة
- طب و صحة
- الثلاثاء-2022-11-15 | 06:29 pm
نيروز الإخبارية :
تفشى مرض الليستيريا في 6 ولايات أمريكية وأصاب 16 شخصا حتى الآن، من بينهم 13 استدعى وضعهم الصحي النقل إلى المستشفى، فماذا تعرف عن المرض؟
كشفت المراكز الأمريكية للسيطرة على الأمراض والوقاية منها CDC أن مرض الليستيريا أسفر عن مقتل شخص واحد وتسبب في فقد حمل واحدة، مع توقعات أن يكون العدد الفعلي للحالات أعلى من المبلغ عنه ولا يقتصر الانتشار على ولاية واحدة.
وبحسب ما ورد، فإن استهلاك اللحوم الباردة التي تشمل اللحوم الباردة والنقانق والجبن يمكن أن يكون مصدرًا محتملاً لتفشي المرض.
وتحقق المراكز الأمريكية للسيطرة على الأمراض والوقاية منها وإدارة الغذاء والدواء الفيدرالية في السبب الجذري الدقيق للانتشار المفاجئ.
وفقا لـCDC وإدارة الغذاء والدواء الأمريكية فهذه بعض أبرز المعلومات عن المرض وطرق الوقاية منها:
- الليستريات عدوى خطيرة تنتج عن تناول طعام ملوث ببكتيريا الليستريا المستوحدة، ويصيب المرض نحو 1600 شخص سنويا يموت منهم 260 شخصًا.
- تم ربط تفشي مرض الليستريا في الماضي في الولايات المتحدة بالحليب الخام غير المبستر والجبن والآيس كريم والخضروات النيئة أو المصنعة والفواكه النيئة أو المصنعة والدواجن النيئة أو غير المطبوخة جيدًا والبرجر واللحوم الباردة والأسماك النيئة أو المدخنة وغيرها من المأكولات البحرية.
- تشكل العدوى تهديدًا كبيرًا لفئات الحوامل وأطفالهن حديثي الولادة، والبالغين الذين تبلغ أعمارهم 65 عامًا أو أكبر، والأشخاص الذين يعانون من ضعف في جهاز المناعة.
- قد يبدأ الأشخاص المصابون بـL. monocytogenes في رؤية الأعراض في غضون ساعات قليلة أو خلال يومين إلى 3 أيام بعد تناول طعام ملوث، و قد تستغرق الأشكال الأكثر شدة من الليستريات ما بين ثلاثة أيام إلى ثلاثة أشهر حتى تظهر.
- تشمل أعراض الليستيريا: آلام العضلات، تيبس الرقبة، حُمى، أعراض الإنفلونزا، غثيان، إسهال، صداع وارتباك.
- من المحتمل أن يمر المرض دون أي مضاعفات ولكن قد يصيب البعض بحالات خطيرة، مثل: الشلل والرعشة وعدوى الدم الخطيرة والتهاب السحايا (التهاب أغشية الدماغ) والإجهاض أو الولادة المبكرة.
لا تستهلك سوى الحليب المبستر ومنتجات الألبان، بما في ذلك الجبن الطري والآيس كريم والزبادي، وابحث عن كلمة "مبستر" على الملصق,
- احتفظ بالحليب ومنتجات الألبان مبردة عند 40 درجة فهرنهايت أو أكثر برودة.
- لا تأكل البراعم النيئة أو المطبوخة قليلاً (الفجل، الفاصوليا).
- تناول قطع البطيخ بعد تقطيعها على الفور أو احتفظ بها في المبرد عند 41 درجة فهرنهايت أو أكثر برودة ولمدة لا تزيد عن 7 أيام.
- بالنسبة للحوم الباردة، يجب تخزين العبوات المفتوحة لمدة لا تزيد عن 3 إلى 5 أيام في الثلاجة والعبوات غير المفتوحة لمدة لا تزيد عن أسبوعين في الثلاجة.
- لا تأكل السمك المدخن البارد ما لم يكن معلبًا أو في طبق مطبوخ مثل الطاجن.
















